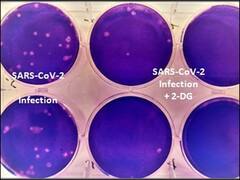
कोरोना मरीजों के लिए 'संजीवनी बूटी' साबित होगी डीआरडीओ की ये दवा ?

एक्सप्लोरर
2 Dg
हेल्थ

Anti-Covid drug 2-DG : नई रिसर्च में दावा- डीआरडीओ की 2-डीजी दवा कोरोना के सभी वैरिएंट कि खिलाफ कारगर
States

Lucknow: आज DRDO अस्पताल पहुंचेगी Corona की 2 DG दवा, पहले चरण में 250 डोज आने की उम्मीद
News

कोरोना के खिलाफ DRDO का नया हथियार 2-DG | मास्टर स्ट्रोक
News

35 दिन बाद देश में आये एक दिन में 3 लाख से कम कोरोना संक्रमण के मामले | इंडिया चाहता है
बिन मांगा ज्ञान

क्या है ये DRDO की कोरोना दवा 2DG और कैसा होगा इसका कोरोना मरीज़ों पर असर बता रहे हैं डॉ अंशुमान कुमार
India

रक्षा मंत्री और स्वास्थ्य मंत्री ने लॉन्च की DRDO की एंटी कोरोना दवा 2DG, जानें कैसे करेगी काम?
News

DRDO की बनाई हुई Corona की दवा 2-DG लॉन्च, Rajnath Singh, Dr Harshvardhan ने किया 2-DG को लॉन्च
India

DRDO की कोरोना दवा 2DG अगले हफ्ते मार्केट में होगी लॉन्च, मरीज तेजी से ठीक होंगे
India
कोरोना मरीजों के लिए 'संजीवनी बूटी' साबित होगी डीआरडीओ की ये दवा ?
India

DCGI ने डीआरडीओ की कोरोना की दवा को दी इमरजेंसी इस्तेमाल की मंज़ूरी, पानी में घोलकर पिलाई जाएगी ये दवाई
News Reels
Advertisement
ट्रेंडिंग न्यूज
Advertisement







































